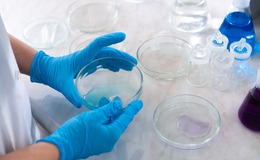

Process control and networking software
Latest Content
Lab roundup: Automata-Crick partnership, EPSRC £2mill, Tetra-Pak milestone
Genomics ramps up the automation, the chance to host a national research facility, a flow cytometry acquisition and more are among the latest business and R&D moves in the lab world...
